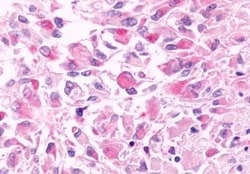
Invitrogen GPR81 Polyclonal Antibody 50 &mu;g; Unconjugated:Antibodies,

missing translation for 'onlineSavingsMsg'
Learn More
Learn More
Invitrogen™ GPR81 Polyclonal Antibody


Rabbit Polyclonal Antibody
Brand: Invitrogen™ PA533765
This item is not returnable.
View return policy
Description
Percent identity with other species by BLAST analysis: Human, Gorilla, Monkey, Marmoset, Rat, Dog, Bat, Hamster, Panda, Rabbit, Opossum (100%).
The G protein-coupled receptor GPCR GPR81 has been reported primarily in adipose and pituitary. ESTs have been isolated from human bladder cancer and colon cancer libraries. It has not been detected in frontal, temporal and occipital lobes of the cortex, basal forebrain, caudate nucleus, nucleus accumbens, and hippocampus.
Specifications
| GPR81 | |
| Polyclonal | |
| Unconjugated | |
| HCAR1 | |
| FKSG80; G protein-coupled receptor 104; G protein-coupled receptor 81; GPR104; GPR81; G-protein coupled receptor 104; G-protein coupled receptor 81; HCA1; HCAR1; hydrocarboxylic acid receptor 1; hydroxycarboxylic acid receptor 1; hydroxy-carboxylic acid receptor 1; LACR1; lactate receptor 1; TAGPCR; TA-GPCR; T-cell activation G protein-coupled receptor | |
| Rabbit | |
| Antigen affinity chromatography | |
| RUO | |
| 100345808, 100766347, 27198, 369158, 486252 | |
| Store at 4°C short term. For long term storage, store at -20°C, avoiding freeze/thaw cycles. | |
| Liquid |
| Immunohistochemistry (Paraffin) | |
| 1 mg/mL | |
| PBS with 0.1% sodium azide | |
| Q9BXC0 | |
| HCAR1 | |
| Synthetic 16 amino acid peptide from 2nd extracellular domain of human GPR81. | |
| 50 μg | |
| Primary | |
| Human, Rat, Canine, Rabbit, Monkey, Hamster, Bat | |
| Antibody | |
| IgG |
Product Content Correction
Your input is important to us. Please complete this form to provide feedback related to the content on this product.
Product Title
Spot an opportunity for improvement?Share a Content Correction